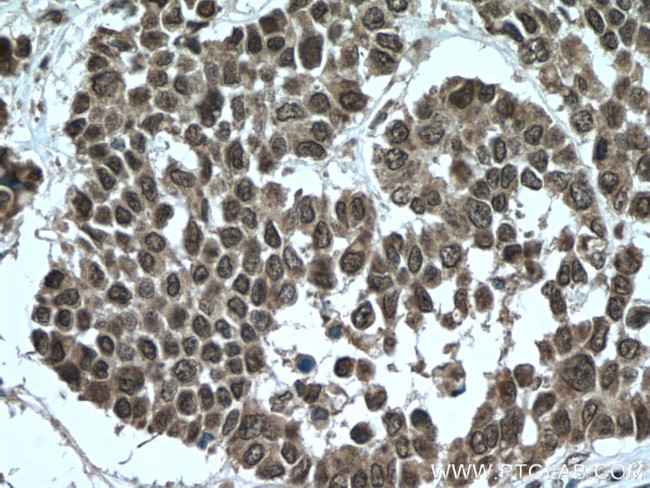
TTC5 Antibody in Immunohistochemistry (Paraffin) (IHC (P))

Search
Proteintech
TTC5 Polyclonal Antibody
{{$productOrderCtrl.translations['antibody.pdp.commerceCard.promotion.promotions']}}
{{$productOrderCtrl.translations['antibody.pdp.commerceCard.promotion.viewpromo']}}
{{$productOrderCtrl.translations['antibody.pdp.commerceCard.promotion.promocode']}}: {{promo.promoCode}} {{promo.promoTitle}} {{promo.promoDescription}}. {{$productOrderCtrl.translations['antibody.pdp.commerceCard.promotion.learnmore']}}
产品信息
26112-1-AP
种属反应
宿主/亚型
分类
类型
抗原
偶联物
形式
浓度
规格
纯化类型
保存液
内含物
保存条件
运输条件
产品详细信息
Immunogen sequence: MMADEEEEV KPILQKLQEL VDQLYSFRDC YFETHSVEDA GRKQQDVRKE MEKTLQQMEE VVGSVQGKAQ VLMLTGKALN VTPDYSPKAE ELLSKAVKLE PELVEAWNQL GEVYWKKGDV AAAHTCFSGA LTHCRNKVSL QNLSMVLRQL RTDTEDEHSH HVMDSVRQAK LAVQMDVHDG RSWYILGNSY LSLYFSTGQN PKISQQALSA YAQAEKVDRK ASSNPDLHLN RATLHKYEES YGEALEGFSR AAALDPAWPE PRQREQQLLE FLDRLTSLLE SKGKVKTKKL QSMLGSLRPA HLGPCSDGHY QSASGQKVTL ELKPLSTLQP GVNSGAVILG KVVFSLTTE (1-348 aa encoded by BC053538 )
靶标信息
Tetratricopeptide repeat protein 5 (TTC5) is a member of a diverse group of functionally distinct proteins that are characterized by containing one or more tetratricopeptide repeats. Each motif consists of two anti-parallel a-helices such that tandem arrays of TPR motifs generate a right-handed helical structure with an amphipathic channel that may serve to accommodate the complementary region of a target protein. While the exact function of TTC5 remains unclear, it is thought that the TPR motifs serve to mediate protein-protein interactions such as those seen with protein chaperones HSP70 and HSP90 and some proteins involved in cell stress response signaling pathways such as protein phosphatase 5, suggesting that TTC5 may also function via protein-protein interactions mediated by its TPR motifs.
仅用于科研。不用于诊断过程。未经明确授权不得转售。
篇参考文献 (0)
生物信息学
蛋白别名: Protein Strap; strap; Stress-responsive activator of p300; Tetratricopeptide repeat protein 5; TPR repeat protein 5; unnamed protein product
基因别名: NEDCAFD; Strap; TTC5
UniProt ID: (Human) Q8N0Z6, (Rat) Q5BK48
Entrez Gene ID: (Human) 91875, (Rat) 305837